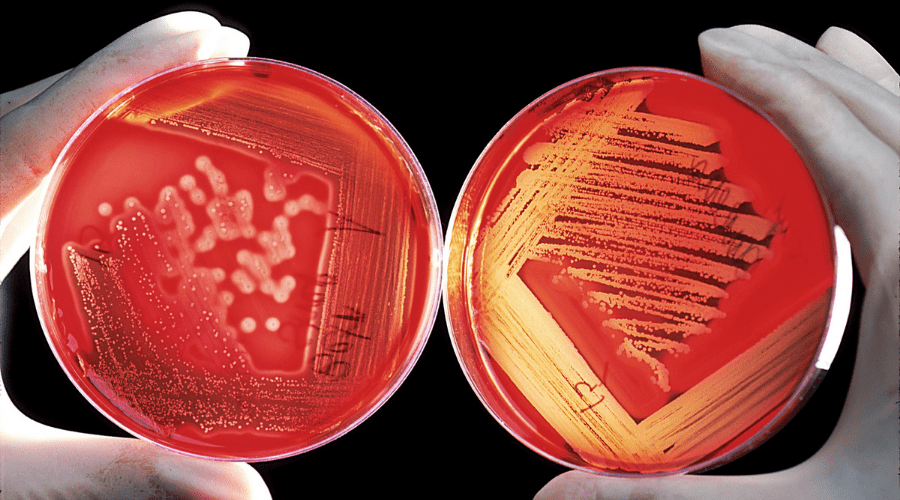
Listeria: ¿Qué es y cómo evitarla? - La Viña

------ªªªASOCIACIÓN EMPRESARIAL DE HOSTELERÍA DE MADRID te informa que los datos que nos facilite a través de este formulario de recogida de datos se utilizarán con el fin de efectuar el registro como usuario de HOSTELERÍA DE MADRID, así como el envío de comunicaciones comerciales con respecto a novedades, noticias e información promocional de HOSTELERÍA MADRID. Legitimación: La ejecución de un contrato en el que el usuario es parte y el consentimiento del usuario en el caso de aceptar la casilla de consentimiento del envío de comunicaciones comerciales. Podrás ejercitar los derechos reconocidos en los artículos 15 a 22 del Reglamento (UE) 2016/679, enviando un correo electrónico a: legal@hosteleriamadrid.com o mediante correo postal a Paseo de Santa María de la Cabeza, 1, 1o centro derecha, Madrid (España), aportando cuanta información sea necesaria para su correcta identificación. Para más información, consulte nuestra Política de Privacidad. Así mismo, se le informa que puede presentar cualquier reclamación ante la AEPD: www.aepd.es

Listeria monocytogenes es una bacteria que se desarrolla intracelularmente y es causante de la listeriosis. Es uno de los patógenos que provoca infecciones alimentarias más violentas, con una tasa de mortalidad entre un 20% a 30%, más alta que casi todas las restantes toxiinfecciones alimentarias.
La característica principal de listeria es su RESISTENCIA, la capacidad de multiplicarse incluso a temperaturas de refrigeración, hace que se deban extremar las precauciones tanto en los procesos de almacenamiento de producto como en las manipulaciones. Se trata de un microorganismo ‘psicotrofo’ que puede desarrollarse a temperaturas frías y en procesos de refrigeración inferiores a 5 °C, aunque la temperatura ideal para su multiplicación está entre los 30-37°C a pH neutro. Es precisamente esta capacidad de desarrollo a temperaturas frías lo que la diferencia de otros gérmenes y la hace más peligrosa.
La listeria monocytogenes se encuentra en el intestino de personas y animales que actúan como portadores, pero también en ambientes naturales como pueden ser el suelo o el agua. En la industria alimentaria, esta bacteria también se encuentra localizada en suelo, paredes, techos y equipos de procesado de alimentos.
Puede transmitirse a las personas a través de la ingestión de alimentos contaminados con ella en cualquier fase en la cadena alimentaria (producción, procesamiento, distribución y la preparación para el posterior consumo). Los alimentos más propensos a contener esta bacteria son aquellos listos para el consumo directo (sin ser cocinados), como son:
- Carnes de fiambre y salchichas.
- Patés.
- Leche y productos lácteos no pasteurizados (crudos).
- Queso blando de leche cruda no pasteurizada, como el queso fresco, Feta, Brie o Camembert.
- Marisco ahumado refrigerado.
- Frutas y verduras: Principalmente brotes, lechugas, rábanos, tomates, cebollas, pepinos, coliflores y setas cultivadas.
- Carne de pollo o cerco poco cocinada.
¿Qué hacer para prevenirla?
- Higiene de manos. Lavar con agua caliente y jabón desinfectante después de manipular alimentos.
- Lavar y desinfectar todas las superficies de trabajo entre manipulaciones de productos distintos y al final de la jornada.
- Los equipos de frio deben de mantenerse por debajo de 4°C.
- Todos los productos almacenados deben de mantenerse etiquetados y protegidos.
- Cocinar las carnes por encima de los 70-75°C.
- Evitar el consumo de leche no pasteurizada o quesos elaborados con leche cruda.
- Evitar el acumulo de agua sucia en sumideros.
- Mantener un control de temperatura exhaustivo en todos los productos del Buffet que sean: ahumados, quesos frescos, patés.
- Realizar una correcta desinfección de frutas y verduras que se vayan a consumir en crudo.
Efectos adversos
Los síntomas habituales de la listeriosis son fiebre, fuerte dolor de cabeza, dolores musculares, náuseas y vómitos, pero puede haber otros más graves en el caso de mujeres embarazadas. Se debe acudir al médico para tratarla con antibiótico.
Redacción: Patricia Mota